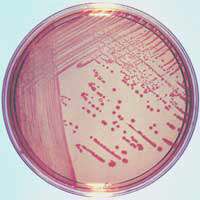

انواع محیط های کشت باکتری
![]() |
محیط کشت آگار خوندار (Blood agar)
محیط کشت عمومی است که به منظور تکثیر و جدا سازی باکتری های بیماریزا به خصوص باکتری هایی که برای رشد به مواد مغذی نیاز دارند، بکار می رود. به علاوه در این محیط وجود همولیزین در باکتری ها را نیز می توان کاوش کرد.
پس از اتوکلاو محیط پایه، هنگامی که درجه آن تا حدود ۵۰ درجه سانتیگراد رسید، خون دفیبرینه گاو را به نسبت ۵ تا ۷ درصد به آن اضافه نموده و با رعایت شرایط استریل در پلیت های استریل می ریزیم.
ممکن است بسته به نوع باکتری یکی از سه حالت ذیل مشاهده گردد:
۱- همولیز کامل β: باکتری واجد آنزیم همولیزین بوده و اطراف پرگنه منطقه شفافی ایجاد می گردد.
۲- همولیز ناقص α: باکتری واجد آنزیم همولیزین بوده ولی نسبت لیز کمتر از ۵۰ درصد می باشد و اطراف پرگنه هاله سبز رنگ ایجاد می گردد.
۳- عدم همولیزγ : باکتری فاقد آنزیم همولیزین می باشد.
محیط کشت آگار شکلاته (Chocolate agar)
اگر به محیط پایه آگار خوندار، هنگامی که درجه حرارت آن بعد از اتوکلاو در حدود ۸۰-۷۰ درجه سانتیگراد باشد، خون دفیبرینه گاو اضافه کنیم، محیط کشت آگار شکلاته به دست می آید. در این محیط به علت این که گلبول های قرمز خون در اثر حرارت متلاشی شده و اجزای آن خارج گشته، برای رشد باکتری هایی نظیر هموفیلوس و نایسریاها که نیاز بیشتری به مواد غذایی آماده دارند مناسب می باشد.
همانند محیط کشت آگار خوندار Blood agar بسته به نوع باکتری همولیز و یا همولیز ناقص و عدم همولیز ایجاد می گردد.
محیط کشت بریلیانت گرین آگار (Briliant green agar)
محیطی است انتخابی و برای جداسازی گونه های سالمونلا به کار می رود. این محیط از رشد بسیاری از باکتری های روده ای (انتروباکتریاسه) به جز سالمونلا جلوگیری می نماید. در صورتی که Ecoli، کلبسیلا و پروتئوس و سایر انترو باکتریاسه ها رشد نمایند، به دلیل اینکه قند لاکتوز و یا سوکروز و یا هر دو را تخمیر می نمایند و تولید اسید می کنند، در مجاورت معرف رنگی فنل رد به رنگ زرد در می آیند. در صورتی که باکتری های لاکتوز منفی مانند سالمونلا رشد نمایند، به دلیل عدم تخمیر قند در مجاورت معرف، محیط به رنگ ارغوانی در می آید.
محیط کشت مک کانکی آگار Macconkey agar
محیط انتخابی است که برای جداسازی و تعیین هویت باکتری های گرم منفی می باشد. املاح صفراوی و کریستال ویوله مانع از رشد باکتری های گرم مثبت می شوند. باکتری های تخمیر کننده ی لاکتوز (لاکتوز مثبت ها) کلنی هایی به رنگ ارغوانی و باکتری هایی که قادر به تخمیر نیستند (لاکتوز منفی ها) کلنی هایی بی رنگ ایجاد می نمایند.
رنگ ارغوانی کلنی های باکتری های لاکتوز مثبت مربوط به واکنش اسیدی است که در نتیجه تخمیر قند لاکتوز در مجاورت املاح صفراوی و جذب نوترال رد حاصل شده است.
معرف نوترال رد در محیط قلیایی بی رنگ و در محیط اسیدی قرمز رنگ است.
محیط کشت سابور دکستروز آگار (Saborad Dextrose agar)
محیط انتخابی برای تکثیر قارچ ها می باشد که بسیاری از باکتری ها نیز در این محیط رشد می کنند. انتخابی بودن این محیط برای قارچ ها بر اساس PH پایین و همچنین مواد غذایی ناچیز آن است.
محیط کشت DNASE
باکتری هایی که حاوی آنزیم دی اکسی ریبو نوکلئاز باشند، هاله صورتی رنگی اطراف کلنی ها پدید می آورند. تولوئیدن آبی در حضور DNA سالم به رنگ آبی است. ولی در صورت ریختن HCL ی نرمال موجب تخریب مولکول DNA شده و این ترکیب به رنگ صورتی در می آید.